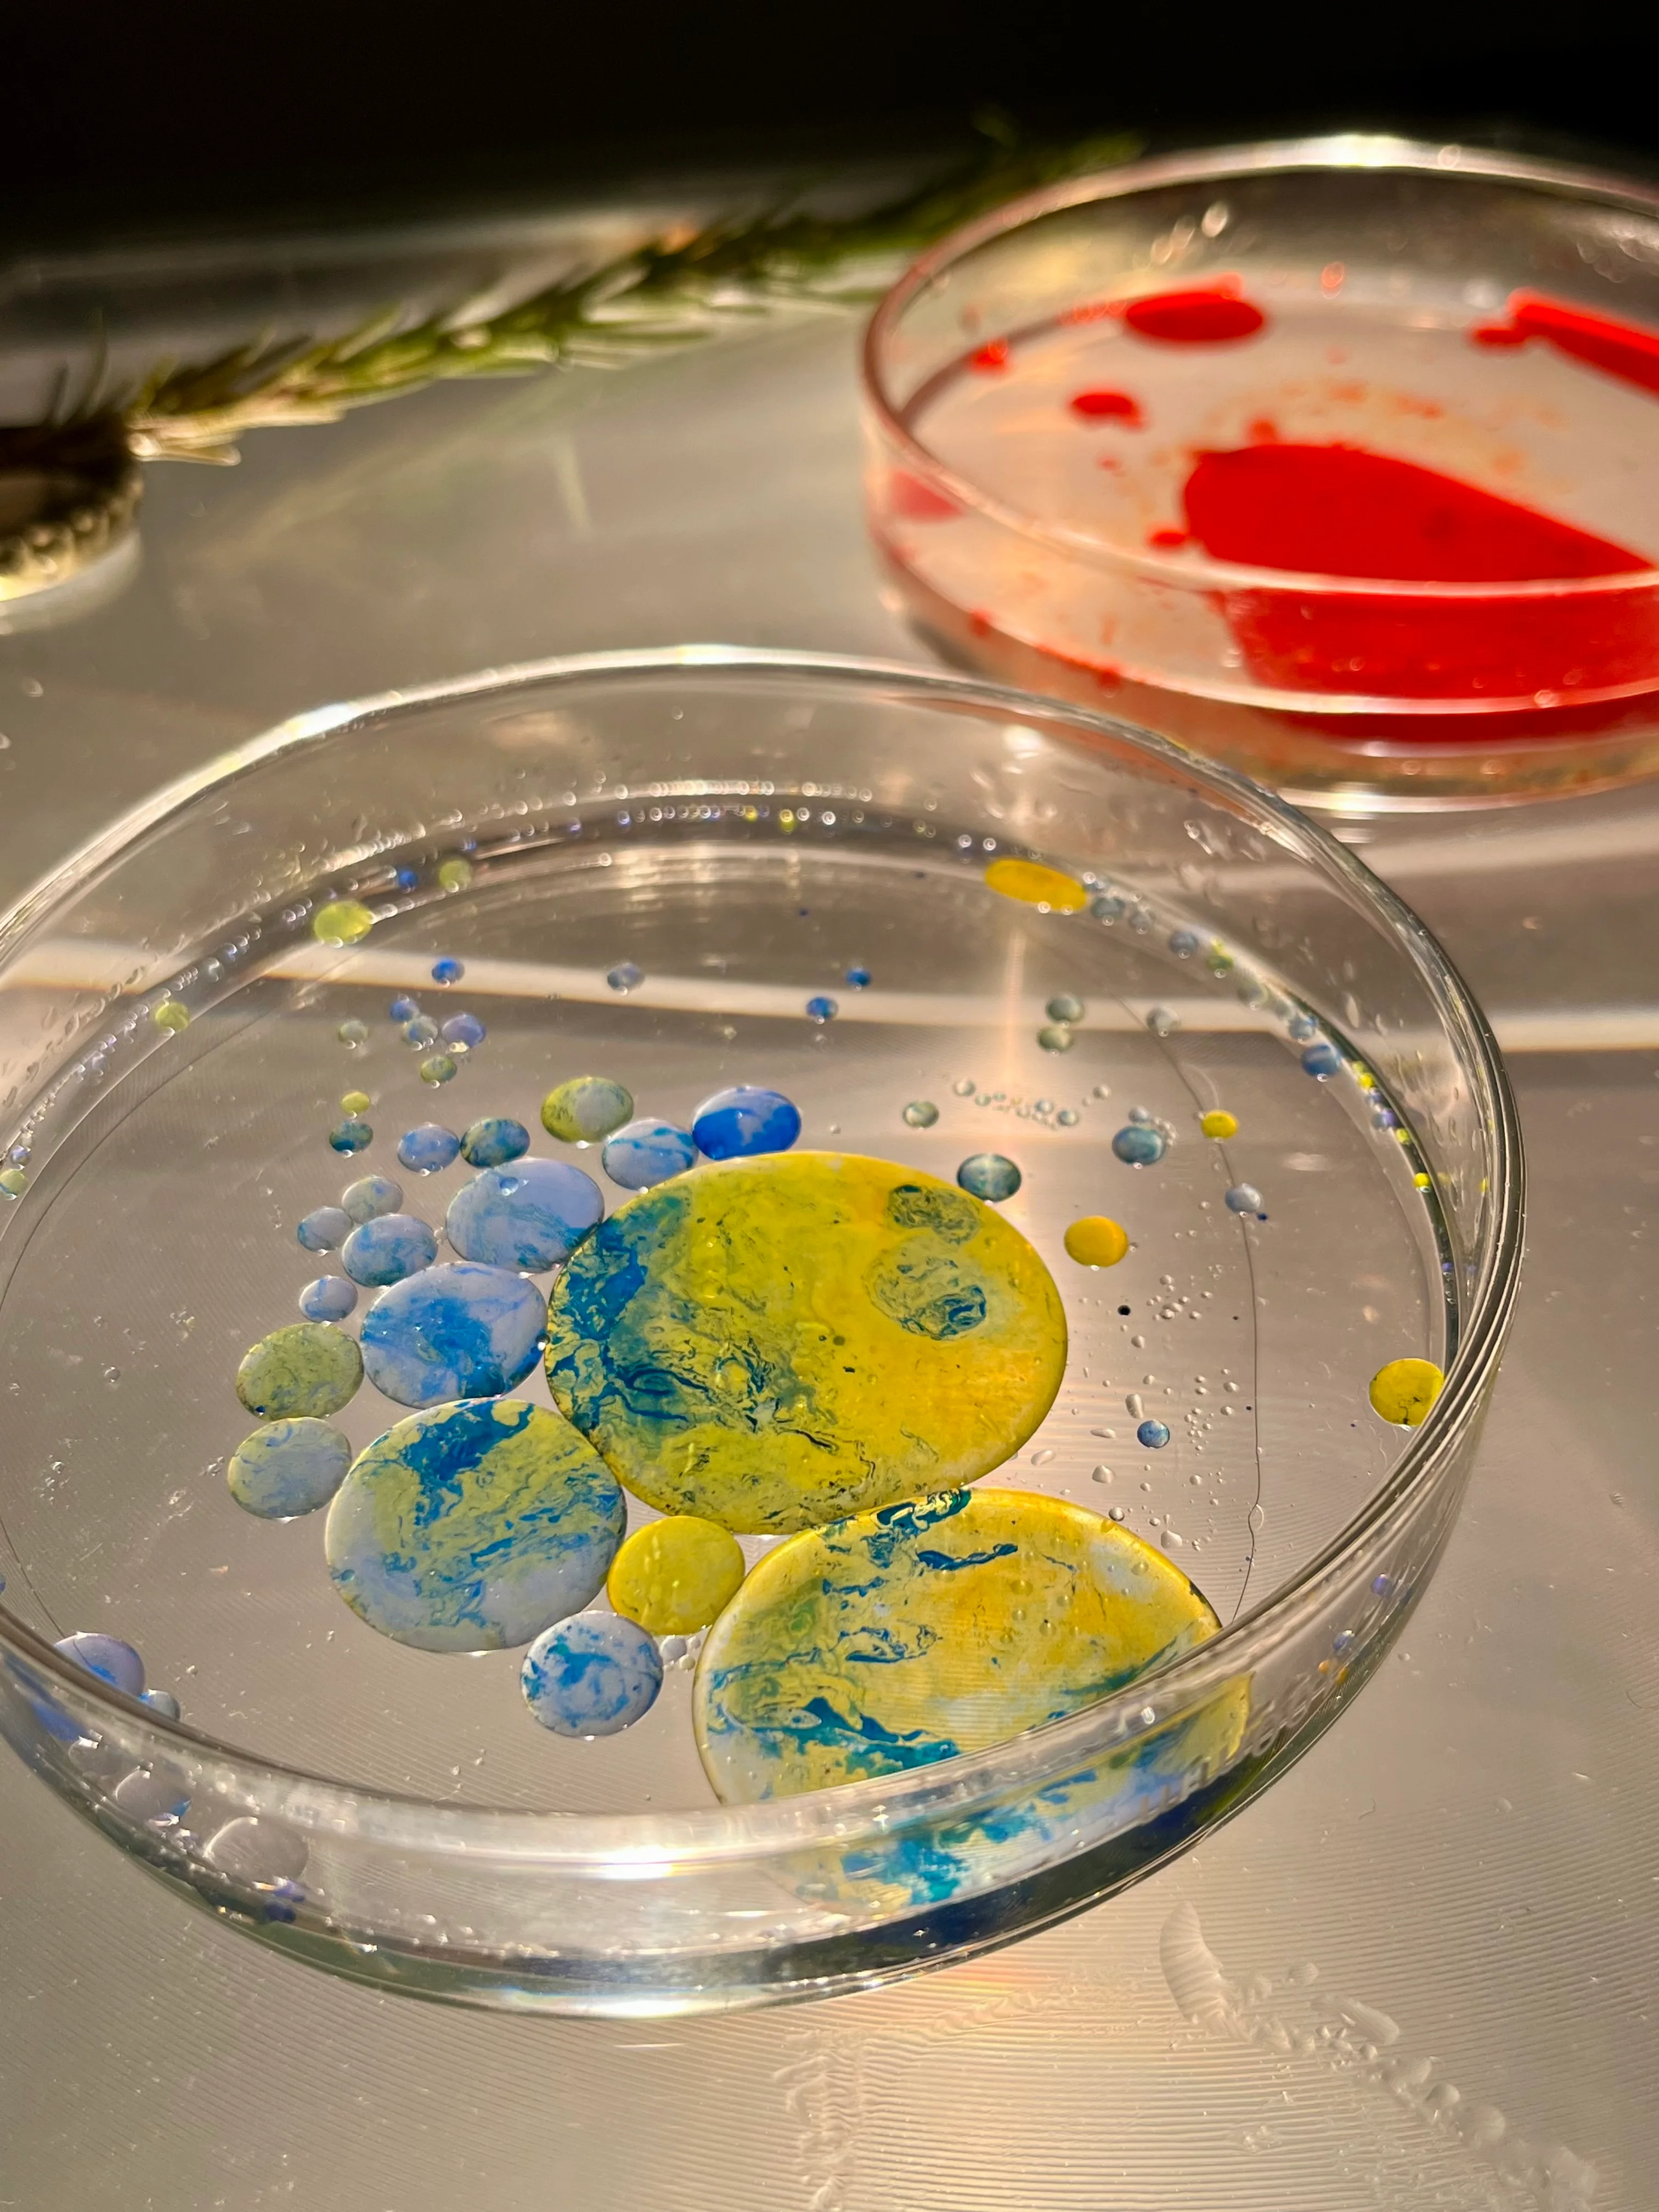
Live coding performance portrait

Hydracelli
Live coding performances using Hydra for real-time visual synthesis. Creating immersive audiovisual experiences for events, installations, and digital art spaces.
Live Coding Session
@Immer Wieder Gerne Festival 08/2025

Live Coding Session
@Immer Wieder Gerne Festival 08/2025

ESP Wifi LED Lamp
@Immer Wieder Gerne Festival 08/2025
ESP32 Wifi LED Lamp
@Immer Wieder Gerne Festival 08/2025
Oil on Alcohol on Polylux
@Private Visual Art
Oil on Alcohol on Polylux
@Private Visual Art